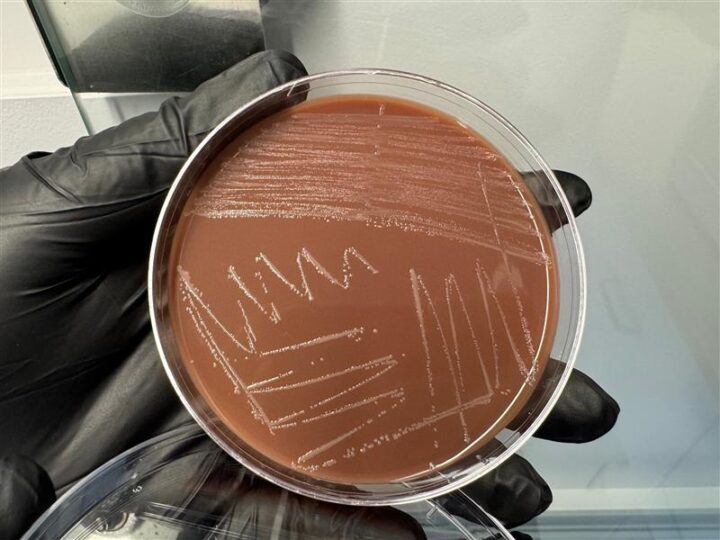
Hand holding petri dish with gonorrhea culture

For the second consecutive year, San Diego County has reported a decline in sexually transmitted infections (STIs), a trend mirrored across California, according to newly released 2024 data from the California Department of Public Health.
STIs are spread through sexual contact involving genitals or bodily fluids, and some can be spread from a pregnant person to a fetus. They can be caused by viruses, bacteria, fungi or parasites.
Anyone who is sexually active can contract an STI, and some can be life-threatening if left untreated. While congenital syphilis cases fell slightly, health officials recorded three fetal deaths (stillbirths) due to the disease in 2024.
Some of the most commonly reported STIs in San Diego County are chlamydia, gonorrhea, and syphilis.
Here are the sexually transmitted infection numbers for 2023–2024, as recorded by the County’s HIV, STD, and Hepatitis Branch of Public Health Services:
- Chlamydia: Down 7.4%, from 17,720 cases in 2023 to 16,414 in 2024. Women ages 20–24 have the highest infection rates.
- Gonorrhea: Decreased 9.5%, from 6,651 cases in 2023 to 6,021 in 2024. Men ages 25–29 show the highest rates.
- Syphilis (Primary & Secondary): Dropped 35.8%, from 481 cases in 2023 to 309 in 2024. Infection rates are highest among men ages 25–34.
Syphilis (Congenital): Dropped 9.5%, from 36 cases in 2023 to 31 cases in 2024. Three stillbirths or neonatal deaths occurred in 2024 (highest since 2019).
County health experts attribute the decreases to many factors, including increased state investment in STI prevention and control at the local level, improved access to routine screening and improvements in diagnostic testing, including rapid or point-of-care tests.
Another likely contributor is the increased use of an antibiotic within 72 hours of condomless sex with a partner determined to be infected. Research has shown that quick use of an antibiotic can significantly reduce syphilis and chlamydia and prevent some gonorrhea infections among certain populations.
“These numbers are encouraging but there is still work to be done,” said Dr. Sayone Thihalolipavan, M.D., M.P.H., County Public Health Officer. “We need to focus on decreasing cases of maternal syphilis, and babies born with congenital syphilis.”
Sexually transmitted infections are common and, in most cases, easily treated. Left untreated, they can lead to serious health issues and continued transmission.
County public health officials recommend that anyone who is sexually active establish a sexual health routine that includes screening, testing, vaccination and regular visits with your health care provider.
The County operates three walk-in sexual health clinics which offer testing, diagnosis, and treatment for STIs. Find more information on the County STD webpage or call (619) 293-4700.